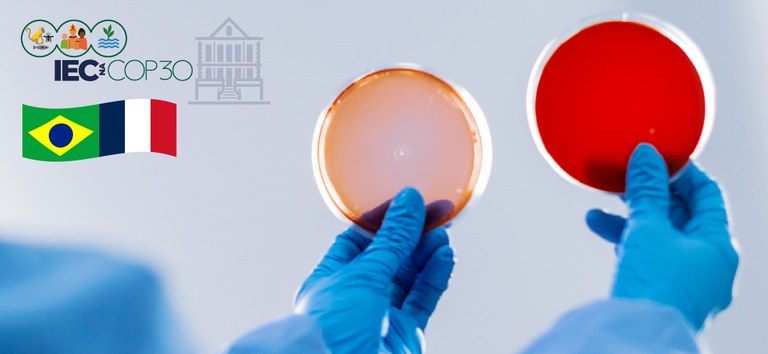
Brasil_França  aliança contra a resistência aos antimicrobianos_COP30_Prancheta 1.jpg

Notícias
Brasil e França reforçam aliança contra a resistência aos antimicrobianos na COP-30
A resistência aos antimicrobianos (RAM), considerada uma das maiores ameaças globais à saúde pública, estará no centro do debate durante a programação “Resistência aos Antimicrobianos e Saúde Única: o compromisso Brasil-França na COP-30”, que ocorrerá na próxima quinta-feira, 13 de novembro, das 16h às 18h, no estande do Instituto Evandro Chagas (IEC), na Green Zone da COP-30, em Belém (PA).
O evento é uma coorganização do IEC, da bioMérieux, da ANRS e da Embaixada da França no Brasil, com o objetivo de fortalecer a agenda estratégica de cooperação internacional para enfrentar a RAM a partir de uma abordagem One Health / Saúde Única − que integra saúde humana, animal e ambiental.
A programação inclui abertura com autoridades brasileiras e francesas, além de palestras e uma mesa-redonda com especialistas nacionais e internacionais.
Abertura: 13/11, das 16h às 16h25
- Ethel Maciel – Enviada Especial para Saúde COP-30 Brasil, professora Titular da Universidade Federal do Espírito Santo e doutora em Epidemiologia;
- Livia Caricio Martins – Diretora IEC/SVSA/MS;
- Leo Teixeira – Vice-presidente e General Manager bioMérieux Brasil;
- Sophie Jacquel – Conselheira Científica, Embaixada da França no Brasil;
- Erica Telford – International Technical Expert, ANRS MIE / Expertise France.
Painel 1 – Resistência aos antimicrobianos e saúde global
Das 16h25 às 16h45
- Ethel Maciel – Enviada Especial para Saúde COP-30 Brasil, professora Titular da Universidade Federal do Espírito Santo e doutora em Epidemiologia;
- Cintya de Oliveira – Pesquisadora IEC/SVSA/MS.
Painel 2 – Resistência aos antimicrobianos na Amazônia: uma perspectiva One Health
Das 16h45 às 17h05
- Lourival Marsola – CCIH CHU-UFPA HJBB.
Painel 3 – Conectando Saúde Única e Saúde Humana: o futuro do diagnóstico e da assistência
Das 17h05 às 17h25
- Ethel Maciel – COP-30;
- Cintya de Oliveira – IEC;
- Lourival Marsola – CHU-UFPA HJBB;
- Sophie Jacquel – Embaixada da França no Brasil.
Mesa-redonda – Parcerias globais contra a RAM: ciência, política e cooperação por um futuro sustentável
Das 17h25 às 17h55
• Convidados das instituições coorganizadoras.
• Moderação: Ruan Fernandes, Medical Advisor Manager na bioMérieux.
Além de discutir o papel do diagnóstico laboratorial na prevenção da RAM e na tomada de decisões clínicas e epidemiológicas, o evento destacará os riscos agravados pela crise climática, que acelera a disseminação de microrganismos resistentes e compromete a eficácia de medicamentos essenciais.
“A COP-30 é um momento histórico para reforçar que clima e saúde são agendas inseparáveis. A resistência antimicrobiana cresce silenciosamente e já provoca milhões de mortes por ano no mundo. Diagnosticar com rapidez e precisão é salvar vidas e preservar a eficácia dos antibióticos para o futuro”, afirma Leo Teixeira, da bioMérieux Brasil.
A programação será transmitida no YouTube do Instituto Evandro Chagas: https://www.youtube.com/@InstitutoEvandroChagas
Serviço:
Resistência aos Antimicrobianos e Saúde Única: o compromisso Brasil-França na COP-30
Data: 13 de novembro de 2025.
Horário: das 16h às 18h.
Estande IEC – Green Zone, COP-30 – Belém (PA).
Transmissão ao vivo: @InstitutoEvandroChagas no YouTube.
Para acessar a programação completa do estande do IEC, acesse: https://bit.ly/3JLf703